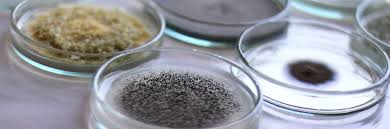

BACHELOR
In questa sezione trovi descrizioni complete dei programmi di bachelor dell'ETH Zurich, suddivisi per materie obbligatorie e a scelta, blocchi tematici, progetti e GESS (Geistes-, Sozial- und Staatswissenschaften).
Ogni programma di bachelor include materiale di studio, strategie di apprendimento, consigli, teoria, formulari, esempi di esami passati e altre risorse accademiche raccolte dagli studenti ticinesi.
Tutti i Programmi

Ingegneria Civile
Il lavoro del Dipartimento di Ingegneria Civile, Ambientale e Geomatica si concentra sulle tematiche al centro delle sfide nazionali e globali del XXI secolo. Le nostre attività di didattica e ricerca si focalizzano sulle opportunità e sul potenziale per una progettazione sostenibile degli spazi abitativi. Grazie a metodi innovativi e a risultati ampiamente riconosciuti, siamo tra le principali istituzioni al mondo per l’insegnamento e la ricerca nei settori dei sistemi strutturali e delle risorse naturali.

Computer Science
ETH Zurich offre un ampio e di alta qualità programma di laurea triennale in informatica, che costituisce una solida base per il futuro lavoro nel campo dell'informatica o in uno dei suoi numerosi settori correlati. Il corso insegna conoscenze fondamentali di matematica e ingegneria elettrica, oltre ai principi base dell'informatica. Oltre alle materie principali come sistemi e ingegneria del software, elaborazione dell'informazione e dei dati, e informatica teorica, gli studenti possono scegliere diversi corsi opzionali in base ai propri interessi personali. La lingua di insegnamento all'inizio del corso di studi è il tedesco. A partire dal secondo anno, i corsi sono progressivamente tenuti in inglese.

Scienze della Terra e del Clima
Il corso di laurea in Clima e Acqua fornisce una conoscenza approfondita delle interazioni tra clima, criosfera, idrosfera e meteorologia. L’obiettivo principale della climatologia è comprendere i processi che determinano il clima e le sue variazioni. L’idrologia si occupa di questioni legate alla gestione delle risorse idriche e fornisce conoscenze fondamentali sul ciclo dell’acqua e le sue relazioni con il clima, la vegetazione, il suolo e la roccia solida. Gli studenti completano i requisiti di corsi obbligatori e opzionali, tirocini, escursioni, corsi sul campo e corsi intensivi, acquisendo così una conoscenza esemplare nei campi dell’atmosfera, del clima e della criosfera. La selezione di argomenti speciali di approfondimento rappresenta un primo passo ideale verso il Master specializzato in Scienze Atmosferiche e del Clima. Le lezioni sono tenute in collaborazione con l’Istituto di Scienze Atmosferiche e del Clima (IAC) presso il Dipartimento di Scienze del Sistema Ambientale.

Ingegneria Elettrica e Tecnologie dell'Informazione
Il Dipartimento di Tecnologie dell’Informazione e Ingegneria Elettrica del Politecnico di Zurigo (ETH Zurich) è impegnato in attività di ricerca e formazione di altissimo livello nel vasto campo dell’ingegneria elettrica e dell’elaborazione elettronica delle informazioni. Inoltre, siamo attivamente coinvolti anche nei settori dell’ingegneria biomedica e della ricerca sul cervello.

Scienze Ambientali
Lo studio delle Scienze Ambientali è dedicato agli sviluppi più recenti nella scienza, nella società e nella politica. Fornisce la capacità di affrontare i problemi ambientali odierni a livello regionale e globale. I corsi offrono conoscenze teoriche e metodologiche e introducono aree di applicazione. Oltre alle scienze naturali, sono presenti anche scienze sociali, discipline umanistiche e materie tecniche. La lingua di insegnamento durante il Bachelor è il tedesco

Scienze e Tecnologia della Salute
Mantenere la salute nella vecchiaia e preservare una buona qualità della vita è una delle principali sfide per la nostra società e i nostri sistemi sanitari. Dall’alimentazione e il microbioma intestinale alla salute fisica e mentale, dalle scienze del movimento e la robotica alla riabilitazione, dai progressi in chimica, biochimica, biologia molecolare e cellulare alla medicina preventiva e rigenerativa, il Dipartimento di Scienze e Tecnologie della Salute riunisce una combinazione unica al mondo di competenze e conoscenze. La ricerca all’intersezione tra ingegneria, neuroscienze, movimento umano, nutrizione e scienze alimentari, così come biologia, medicina e scienze sociali, è di crescente importanza sia per la società che per l’economia.

Medicina
Il percorso attraverso il Politecnico di Zurigo (ETH Zurich) per il conseguimento del titolo di Bachelor e una delle sue università partner per il titolo di Master costituisce le basi per una formazione in medicina umana che apre le porte a scambi con il mondo della scienza e spiana la strada a nuovi sviluppi e tecnologie. L’approfondimento dei metodi utilizzati attualmente, ad esempio nei campi della medicina personalizzata e dell’ingegneria medica, consente una comprensione più approfondita delle opportunità e dei limiti dei futuri metodi di trattamento. Una volta completato il programma di studi della durata di sei anni, i laureati devono ottenere il diploma federale svizzero in medicina umana e svolgere un periodo di lavoro come medico assistente, prima di poter esercitare attività cliniche. È anche possibile accedere direttamente a diversi ambiti professionali (ricerca, consulenza).
Scienze dei Materiali
La scienza dei materiali è una disciplina interdisciplinare che unisce le scienze naturali e l'ingegneria, con applicazioni utili che si ritrovano ovunque nella vita quotidiana. Che si tratti di progetti ingegneristici creativi, concetti fisici e chimici affascinanti o una comprensione di base della matematica e della programmazione, lo studio della scienza dei materiali è vario ed emozionante.

Matematica
La matematica è centrale nella scienza e nella società contemporanea. Il Dipartimento di Matematica dell’ETH Zurich, con sede nello storico edificio principale, è un centro di riferimento internazionale per la ricerca e l’insegnamento in matematica pura e applicata. Comprende cattedre indipendenti, il SAM, il SfS e l’IFOR, e beneficia del supporto dell’Istituto di Ricerca Matematica (FIM), che promuove attivamente la diffusione di idee attraverso un ampio programma di visiting. Il Dipartimento collabora strettamente con l’ETH Institute for Theoretical Studies, il Centro SwissMAP, altri dipartimenti dell’ETH e l’Università di Zurigo. Inoltre, tramite il RiskLab, è attivo nella modellazione statistica e gestione del rischio nei settori assicurativo e finanziario.

Ingegneria Meccanica
Il Bachelor in Ingegneria Meccanica fornisce agli studenti una solida base di conoscenze teoriche. Inoltre, agli studenti viene insegnata la metodologia necessaria per svolgere attività di ricerca nelle discipline della matematica, delle scienze naturali e dell’ingegneria. Il titolo di “Bachelor of Science ETH in Ingegneria Meccanica” permette di proseguire gli studi presso l’ETH di Zurigo o un’altra università in Svizzera o all’estero, a livello di Master.

Fisica
Il curriculum del Bachelor in Fisica è strettamente collegato a quello in Matematica. Questo abbinamento è ulteriormente completato dall’Informatica, che dispone di un proprio curriculum separato. La stretta connessione tra Matematica e Fisica permette agli studenti del primo anno di passare facilmente da un programma all'altro. Il programma di Bachelor del Dipartimento di Fisica è insegnato in lingua tedesca. Parallelamente alle lezioni di Fisica Sperimentale, gli studenti svolgono moduli pratici nei Laboratori di Fisica 1 e 2 (terzo e quarto semestre) e nei Laboratori di Fisica 3 e 4 (quinto e sesto semestre).
Struttura dei Programmi
Materie Obbligatorie
Corsi fondamentali richiesti per ogni programma di bachelor
Materie a Scelta
Corsi elettivi per personalizzare il proprio percorso di studi
GESS
Geistes-, Sozial- und Staatswissenschaften - materie umanistiche e sociali
Progetti
Lavori pratici e progetti di gruppo per applicare le conoscenze teoriche
Risorse Disponibili
Materiale di Studio
Appunti, riassunti e guide di studio condivise dagli studenti
Formulari
Raccolte di formule e riferimenti rapidi per gli esami
Esami Passati
Esempi di esami precedenti con soluzioni e spiegazioni
Hai dubbi sulla scelta del programma?
La nostra comunità di studenti ticinesi è qui per aiutarti. Confrontati con chi ha già esperienza nei diversi programmi di bachelor per fare la scelta migliore.